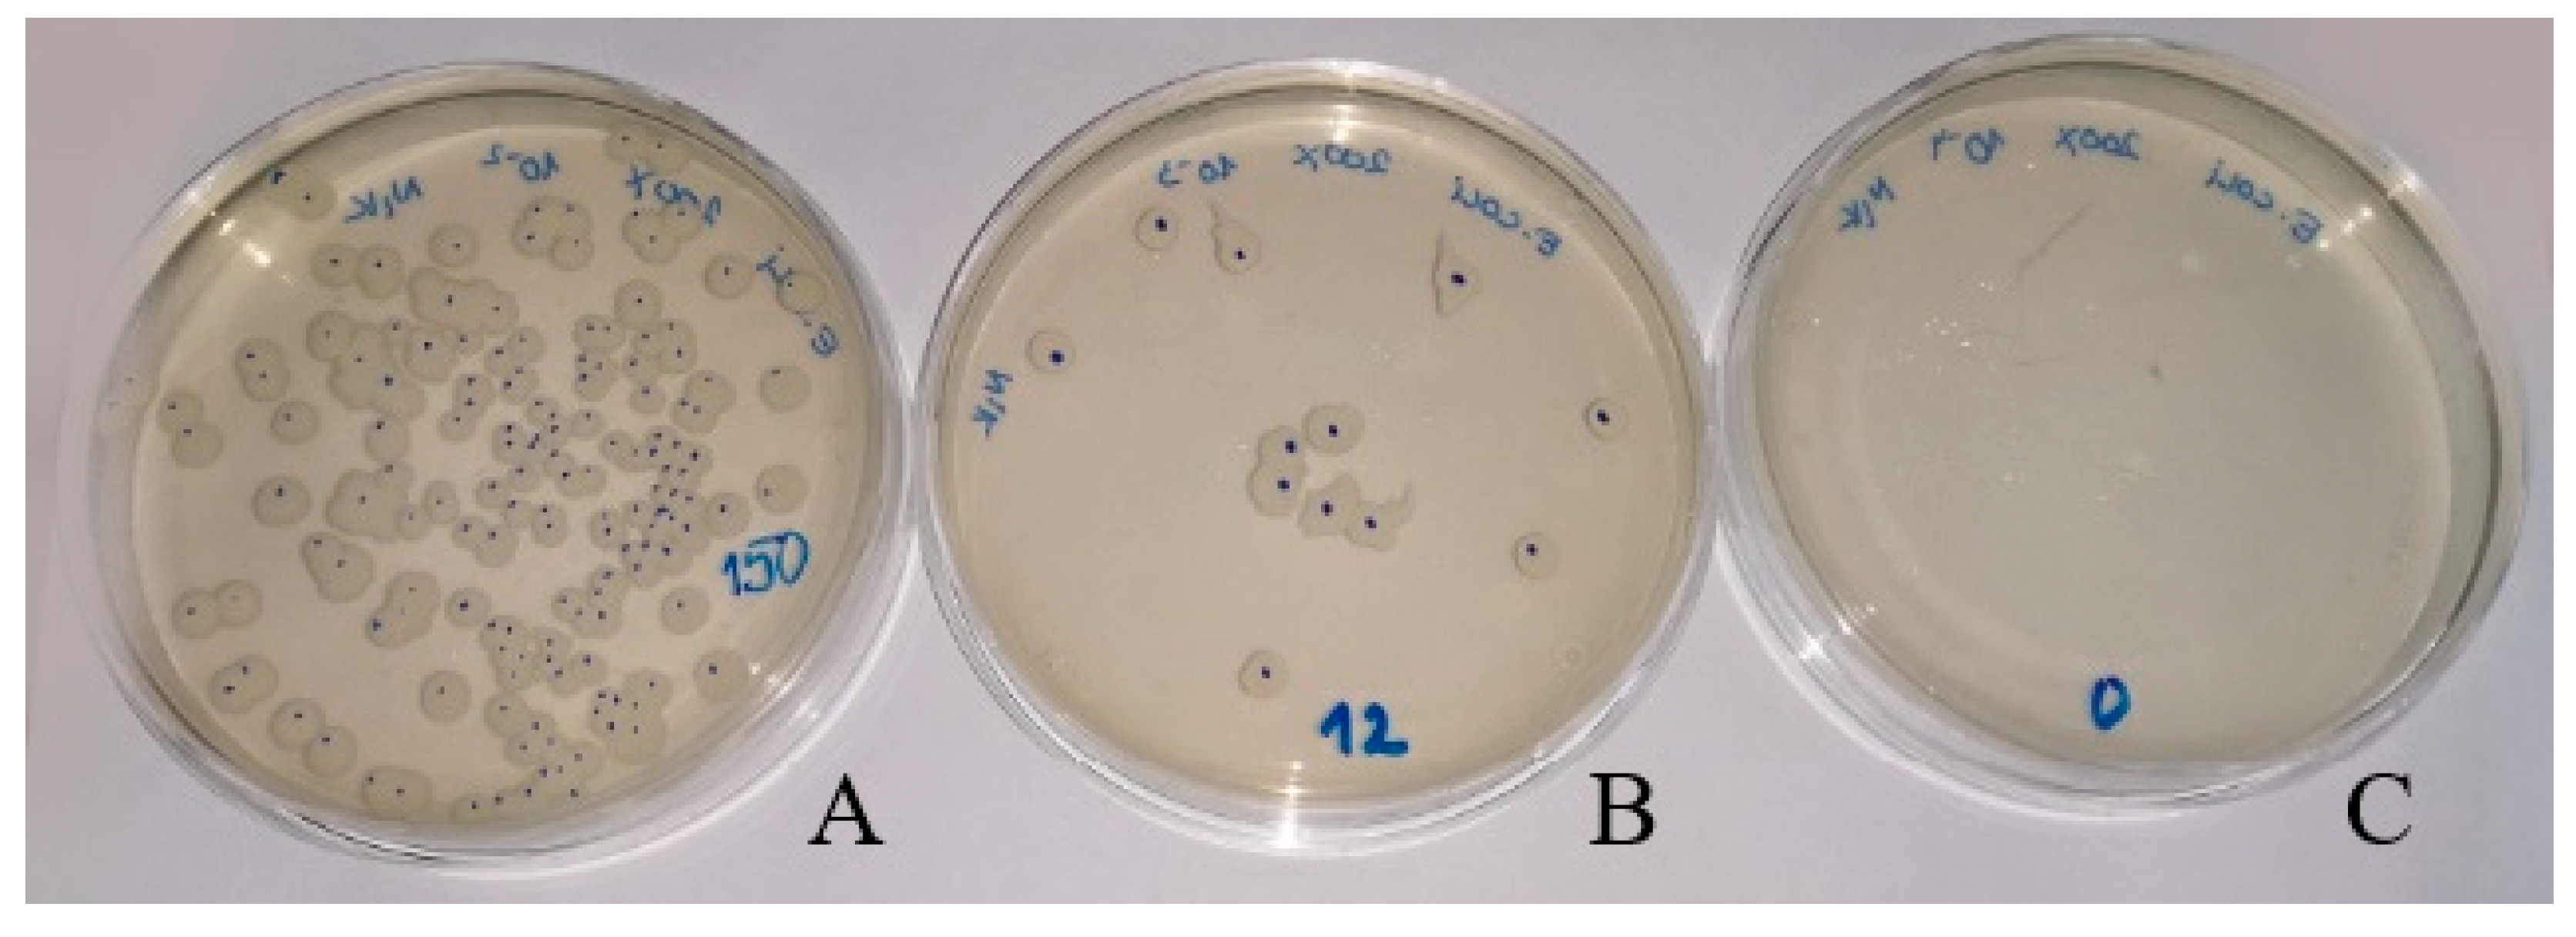
Molecules 24 02432 g006 Molecules 24 02432 g006

Polyolefin/ZnO Composites Prepared by Melt Processing
Abstract
1. Introduction
2. Results and Discussion
2.1. Characterization of ZnO Nanofillers
2.2. Composites of Nano ZnO with HDPE and PP Matrices; Unmodified ZnO and Surface-Modified ZnO with Stearic Acid
2.3. Composites of Nano ZnO with HDPE and PP Matrix—ZnO Surface Modified with Silanes
2.4. Antibacterial Properties of Polyolefin Composites with ZnO Nanoparticles
3. Materials and Methods
3.1. Materials
3.2. Preparation of Polyolefin/ZnO Composites
3.3. Characterization
4. Conclusions
Supplementary Materials
Author Contributions
Funding
Acknowledgments
Conflicts of Interest
References
- Jancar, J.; Douglas, J.F.; Starr, F.W.; Kumar, S.K.; Cassagnau, P.; Lesser, A.J.; Sternstein, S.S.; Buehler, M.J. Current issues in research on structure–property relationships in polymer nanocomposites. Polymer 2010, 51, 3321–3343. [Google Scholar] [CrossRef]
- De Salzano, M.S.; Galizia, M.; Wojnarowicz, J.; Rosa, R.; Lojkowski, W.; Leonelli, C.; Acierno, D.; Filippone, G. Dispersing hydrophilic nanoparticles in hydrophobic polymers: HDPE/ZnO nanocomposites by a novel template-based approach. eXPRESS Polym. Lett. 2014, 8, 362–372. [Google Scholar] [CrossRef]
- Balazs, A.C.; Emrick, T.; Russell, T.P. Nanoparticle Polymer Composites: Where Two Small Worlds Meet. Science 2006, 314, 1107–1110. [Google Scholar] [CrossRef] [PubMed]
- Demir, M.M.; Wegner, G. Challenges in the Preparation of Optical Polymer Composites With Nanosized Pigment Particles: A Review on Recent Efforts. Macromol. Mater. Eng. 2012, 297, 838–863. [Google Scholar] [CrossRef]
- Peponi, L. Morphology-properties relationship on nanocomposite films based on poly(styrene-block-diene-block-styrene) copolymers and silver nanoparticles. Express Polym. Lett. 2011, 5, 104–118. [Google Scholar] [CrossRef]
- Chow, W.S. Effects of SEBS-g-MAH on the properties of injection moulded poly(lactic acid)/nano-calcium carbonate composites. Express Polym. Lett. 2012, 6, 503–510. [Google Scholar] [CrossRef]
- Li, Y.-N.; Li, S.-C.; Li, S. Mechanical and antibacterial properties of modified nano-ZnO/high-density polyethylene composite films with a low doped content of nano-ZnO. J. Appl. Polym. Sci. 2010, 116, 2965–2969. [Google Scholar] [CrossRef]
- Pahovnik, D.; Orel, Z.C.; Kos, T.; Anžlovar, A.; Žagar, E.; Žigon, M. Zinc-Containing Block Copolymer as a Precursor for the in situ Formation of Nano ZnO and PMMA/ZnO Nanocomposites. Macromolecules 2013, 46, 6942–6948. [Google Scholar]
- Anzlovar, A. Polyol mediated nano size zinc oxide and nanocomposites with poly(methyl methacrylate). Express Polym. Lett. 2011, 5, 604–619. [Google Scholar] [CrossRef]
- Anžlovar, A.; Marinšek, M.; Orel, Z.C.; Žigon, M. Basic zinc carbonate as a precursor in the solvothermal synthesis of nano-zinc oxide. Mater. Des. 2015, 86, 347–353. [Google Scholar] [CrossRef]
- Yang, Z.; Zong, X.; Ye, Z.; Zhao, B.; Wang, Q.; Wang, P. The application of complex multiple forklike ZnO nanostructures to rapid and ultrahigh sensitive hydrogen peroxide biosensors. Biomaterials 2010, 31, 7534–7541. [Google Scholar] [CrossRef] [PubMed]
- Kogej, K.; Orel, Z.C.; Anžlovar, A.; Žigon, M. Impact of Inorganic Hydroxides on ZnO Nanoparticle Formation and Morphology. Cryst. Growth Des. 2014, 14, 4262–4269. [Google Scholar]
- Anžlovar, A.; Orel, Z.C.; Kogej, K.; Žigon, M. Polyol-Mediated Synthesis of Zinc Oxide Nanorods and Nanocomposites with Poly(methyl methacrylate). J. Nanomater. 2012, 2012, 1–9. [Google Scholar] [CrossRef]
- Djurišić, A.B.; Leung, Y.H. Optical Properties of ZnO Nanostructures. Small 2006, 2, 944–961. [Google Scholar] [CrossRef] [PubMed]
- Abou-Kandil, A.I.; Awad, A.; Mwafy, E. Polymer nanocomposites part 2: Optimization of zinc oxide/high-density polyethylene nanocomposite for ultraviolet radiation shielding. J. Thermoplast. Comp. Mater. 2015, 28, 1583–1598. [Google Scholar] [CrossRef]
- Yang, R.; Li, Y.; Yu, J. Photo-stabilization of linear low density polyethylene by inorganic nano-particles. Polym. Degrad. Stab. 2005, 88, 168–174. [Google Scholar] [CrossRef]
- Podbršček, P.; Dražič, G.; Anžlovar, A.; Orel, Z.C. The preparation of zinc silicate/ZnO particles and their use as an efficient UV absorber. Mater. Res. Bull. 2011, 46, 2105–2111. [Google Scholar] [CrossRef]
- Anžlovar, A.; Kržan, A.; Žagar, E. Degradation of PLA/ZnO and PHBV/ZnO composites prepared by melt processing. Arab. J. Chem. 2018, 11, 343–352. [Google Scholar] [CrossRef]
- Yang, R.; Christensen, P.; Egerton, T.; White, J. Degradation products formed during UV exposure of polyethylene–ZnO nano-composites. Polym. Degrad. Stab. 2010, 95, 1533–1541. [Google Scholar] [CrossRef]
- Sawai, J.; Igarashi, H.; Hashimoto, A.; Kokugan, T.; Shimizu, M. Effect of Ceramic Powder Slurry on Spores of Bacillus subtilis. J. Chem. Eng. Jpn. 1995, 28, 556–561. [Google Scholar] [CrossRef]
- Sawai, J.; Yoshikawa, T. Quantitative evaluation of antifungal activity of metallic oxide powders (MgO, CaO and ZnO) by an indirect conductimetric assay. J. Appl. Microbiol. 2004, 96, 803–809. [Google Scholar] [CrossRef] [PubMed]
- Ozmıhci, F.O.; Balkose, D. Effects of Particle Size and Electrical Resistivity of Filler on Mechanical, Electrical, and Thermal Properties of Linear Low Density Polyethylene–Zinc Oxide Composites. J. Appl. Polym. Sci. 2013, 130, 2734–2743. [Google Scholar] [CrossRef]
- Hong, J.I.; Schadler, L.S.; Siegel, R.W.; Mårtensson, E. Rescaled electrical properties of ZnO/low density polyethylene nanocomposites. Appl. Phys. Lett. 2003, 82, 1956–1958. [Google Scholar] [CrossRef]
- Wang, X.; Zhang, P.; Hong, R. Preparation and application of aluminum-doped zinc oxide powders via precipitation and plasma processing method. J. Appl. Polym. Sci. 2015, 132, 41990. [Google Scholar] [CrossRef]
- Esmailzadeh, H.; Sangpour, P.; Shahraz, F.; Hejazi, J.; Khaksar, R. Effect of nanocomposite packaging containing ZnO on growth of Bacillus subtilis and Enterobacter aerogenes. Mater. Sci. Eng. C 2016, 58, 1058–1063. [Google Scholar] [CrossRef] [PubMed]
- Esthappan, S.K.; Nair, A.B.; Joseph, R. Effect of crystallite size of zinc oxide on the mechanical, thermal and flow properties of polypropylene/zinc oxide nanocomposites. Compos. Part B Eng. 2015, 69, 145–153. [Google Scholar] [CrossRef]
- Zhou, J.P.; Qiu, K.Q.; Fu, W.L. The Surface Modification of ZnOw and its Effect on the Mechanical Properties of Filled Polypropylene Composites. J. Compos. Mater. 2005, 39, 1931–1941. [Google Scholar] [CrossRef]
- Helal, E.; Pottier, C.; David, E.; Frechette, M.; Demarquette, N. Polyethylene/thermoplastic elastomer/Zinc Oxide nanocomposites for high voltage insulation applications: Dielectric, mechanical and rheological behavior. Eur. Polym. J. 2018, 100, 258–269. [Google Scholar] [CrossRef]
- Lepot, N.; Van Bael, M.K.; Van den Rul, H.; D’Haen, J.; Peeters, R.; Franco, D.; Mullens, J. Influence of Incorporation of ZnO Nanoparticles and Biaxial Orientation on Mechanical and Oxygen Barrier Properties of Polypropylene Films for Food Packaging Applications. J. Appl. Polym. Sci. 2011, 120, 1616–1623. [Google Scholar] [CrossRef]
- Altan, M.; Yildirim, H. Effects of compatibilizers on mechanical and antibacterial properties of injection molded nano-ZnO filled polypropylene. J. Compos. Mater. 2012, 46, 3189–3199. [Google Scholar] [CrossRef]
- Wang, Y.; Shi, J.; Han, L.; Xiang, F. Crystallization and mechanical properties of T-ZnOw/HDPE composites. Mater. Sci. Eng. A 2009, 501, 220–228. [Google Scholar] [CrossRef]
- Zeng, A.; Zheng, Y.; Guo, Y.; Qiu, S.; Cheng, L. Effect of tetra-needle-shaped zinc oxide whisker (T-ZnOw) on mechanical properties and crystallization behavior of isotactic polypropylene. Mater. Des. 2012, 34, 691–698. [Google Scholar] [CrossRef]
- Hayashi, S.; Nakamori, N.; Kanamori, H. Generalized Theory of Average Dielectric Constant and Its Application to Infrared Absorption by ZnO Small Particles. J. Phys. Soc. Jpn. 1979, 46, 176–183. [Google Scholar] [CrossRef]
- Kleinwechter, H.; Janzen, C.; Knipping, J.; Wiggers, H.; Roth, P. Formation and properties of ZnO nano-particles from gas phase synthesis processes. J. Mater. Sci. 2002, 37, 4349–4360. [Google Scholar] [CrossRef]
- Mishra, S.; Srivastava, R.; Prakash, S.; Yadav, R.S.; Panday, A. Photoluminescence and photoconductive characteristics of hydrothermally synthesized ZnO nanoparticles. Opto-Electron. Rev. 2010, 18, 467–473. [Google Scholar] [CrossRef]
- Shalish, I.; Temkin, H.; Narayanamurti, V. Size-dependent surface luminescence in ZnO nanowires. Phys. Rev. B 2004, 69. [Google Scholar] [CrossRef]
- Heller, R.B.; McGannon, J.; Weber, A.H. Precision Determination of the Lattice Constants of Zinc Oxide. J. Appl. Phys. 1950, 21, 1283. [Google Scholar] [CrossRef]
- Silvestre, C.; Cimmino, S.; Pezzuto, M.; Marra, A.; Ambrogi, V.; Dexpert-Ghys, J.; Verelst, M.; Augier, S.; Romano, I.; Duraccio, D. Preparation and characterization of isotactic polypropylene/zinc oxide microcomposites with antibacterial activity. Polym. J. 2013, 45, 938–945. [Google Scholar] [CrossRef]
- Allen, N.S.; Edge, M.; Corrales, T.; Catalina, F. Stabiliser interactions in the thermal and photooxidation of titanium dioxide pigmented polypropylene films. Polym. Degrad. Stab. 1998, 61, 139–149. [Google Scholar] [CrossRef]
- Rouillon, C.; Bussiere, P.-O.; Desnoux, E.; Collin, S.; Vial, C.; Therias, S.; Gardette, J.-L. Is carbonyl index a quantitative probe to monitor polypropylene photo degradation? Polym. Degrad. Stab. 2016, 128, 200–208. [Google Scholar] [CrossRef]
- Kumar, R.; Umar, A.; Kumar, G.; Nalwa, H.S. Antimicrobial properties of ZnO nanomaterials: A review. Ceram. Int. 2017, 43, 3940–3961. [Google Scholar] [CrossRef]
- Altan, M.; Yildirim, H. Comparison of Antibacterial Properties of Nano TiO2 and ZnO Particle Filled Polymers. Acta Phys. Pol. A 2014, 125, 645–647. [Google Scholar] [CrossRef]
- Jain, A.; Bhargava, R.; Poddar, P. Probing interaction of Gram-positive and Gram-negative bacterial cells with ZnO nanorods. Mater. Sci. Eng. C 2013, 33, 1247–1253. [Google Scholar] [CrossRef] [PubMed]
- Aal, N.A.; Al-Hazmi, F.; Al-Ghamdi, A.A.; Al-Ghamdi, A.; El-Tantawy, F.; Yakuphanoglu, F. Novel rapid synthesis of zinc oxide nanotubes via hydrothermal technique and antibacterial properties. Spectrochim. Acta Part A Mol. Biomol. Spectrosc. 2015, 135, 871–877. [Google Scholar] [CrossRef] [PubMed]
- Tam, K.; Djurišić, A.; Chan, C.; Xi, Y.; Tse, C.; Leung, Y.; Chan, W.; Leung, F.; Au, D. Antibacterial activity of ZnO nanorods prepared by a hydrothermal method. Thin Solid Films 2008, 516, 6167–6174. [Google Scholar] [CrossRef]
Sample Availability: Samples of the compounds are not available from the authors. |

| Designation of Samples | Polymer Matrix | Type of Nano ZnO | Type of Modification | Amount of Modifier (wt%) |
|---|---|---|---|---|
| PEZnO-1 | HDPE | Zinkox-aktiv | - | - |
| PEZnO-2 | HDPE | Zano 20 | - | - |
| PEZnO-3 | HDPE | Zano 20 | Stearic acid | 3.0 |
| PEZnO-4 | HDPE | Zano 20 Plus | Caprylyl silane | 3.9 |
| PPZnO-1 | PP | Zinkox-aktiv | - | - |
| PPZnO-2 | PP | Zano 20 | - | - |
| PPZnO-3 | PP | Zinkox-aktiv | Stearic acid | 3.0 |
| Designation of Samples | Type of Nano ZnO | Ref. (t = 0) | Ref. (t = 24 h) | Sample (t = 24 h) | U0 | Ut | At (log10 (CFU/mL)) | R | Score |
|---|---|---|---|---|---|---|---|---|---|
| [CFU/mL] | [CFU/mL] | [CFU/mL] | |||||||
| PEZnO-1 | Zinkox-aktiv | 3.9 × 103 | 3.6 × 103 | 3.1 × 101 | 3.39 | 3.35 | 1.29 | 2.06 | Good |
| PEZnO-2 | Zano 20 | 3.9 × 103 | 3.6 × 103 | 1 | 3.39 | 3.35 | −0.20 | 3.55 | Excellent |
| PEZnO-3 | Zano 20 | 3.9 × 103 | 3.6 × 103 | 4.2 × 102 | 3.39 | 3.35 | 2.42 | 0.92 | Poor |
| PEZnO-4 | Zano 20 Plus | 3.9 × 103 | 3.6 × 103 | 1.3 × 103 | 3.39 | 3.35 | 2.91 | 0.44 | Bad |
| PPZnO-1 | Zinkox-aktiv | 3.8 × 103 | 3.6 × 103 | 4.4 × 102 | 3.38 | 3.35 | 2.44 | 0.91 | Poor |
| PPZnO-2 | Zano 20 | 3.8 × 103 | 3.6 × 103 | 3 | 3.38 | 3.35 | 0.27 | 3.08 | Excellent |
| PPZnO-3 | Zinkox-aktiv | 3.8 × 103 | 3.6 × 103 | 5.9 × 102 | 3.38 | 3.35 | 2.56 | 0.78 | Poor |
| Designation of Samples | Type of Nano ZnO | Ref. (t = 0) | Ref. (t = 24 h) | Sample (t = 24 h) | U0 | Ut | At (log10(CFU/mL)) | R | Score |
|---|---|---|---|---|---|---|---|---|---|
| [CFU/mL] | [CFU/mL] | [CFU/mL] | |||||||
| PEZnO-1 | Zinkox-aktiv | 1.1 × 104 | 1.2 × 104 | 1.5 | 3.83 | 3.89 | −0.03 | 3.91 | Excellent |
| PEZnO-2 | Zano 20 | 1.1 × 104 | 1.2 × 104 | 0.5 | 3.83 | 3.89 | −0.50 | 4.39 | Excellent |
| PEZnO-3 | Zano 20 | 1.1 × 104 | 1.2 × 104 | 1 | 3.83 | 3.89 | −0.03 | 4.09 | Excellent |
| PEZnO-4 | Zano 20 Plus | 1.1 × 104 | 1.2 × 104 | 2 | 3.83 | 3.89 | 0.10 | 3.79 | Excellent |
| PPZnO-1 | Zinkox-aktiv | 8.7 × 103 | 8.4 × 103 | 1 | 3.73 | 3.72 | −0.20 | 3.92 | Excellent |
| PPZnO-2 | Zano 20 | 8.7 × 103 | 8.4 × 103 | 0.5 | 3.73 | 3.72 | −0.50 | 4.22 | Excellent |
| PPZnO-3 | Zinkox-aktiv | 8.7 × 103 | 8.4 × 103 | 1.5 | 3.73 | 3.72 | −0.03 | 3.75 | Excellent |
© 2019 by the authors. Licensee MDPI, Basel, Switzerland. This article is an open access article distributed under the terms and conditions of the Creative Commons Attribution (CC BY) license (http://creativecommons.org/licenses/by/4.0/).
Share and Cite
Anžlovar, A.; Primožič, M.; Švab, I.; Leitgeb, M.; Knez, Ž.; Žagar, E. Polyolefin/ZnO Composites Prepared by Melt Processing. Molecules 2019, 24, 2432. https://doi.org/10.3390/molecules24132432
Anžlovar A, Primožič M, Švab I, Leitgeb M, Knez Ž, Žagar E. Polyolefin/ZnO Composites Prepared by Melt Processing. Molecules. 2019; 24(13):2432. https://doi.org/10.3390/molecules24132432
Chicago/Turabian StyleAnžlovar, Alojz, Mateja Primožič, Iztok Švab, Maja Leitgeb, Željko Knez, and Ema Žagar. 2019. "Polyolefin/ZnO Composites Prepared by Melt Processing" Molecules 24, no. 13: 2432. https://doi.org/10.3390/molecules24132432
APA StyleAnžlovar, A., Primožič, M., Švab, I., Leitgeb, M., Knez, Ž., & Žagar, E. (2019). Polyolefin/ZnO Composites Prepared by Melt Processing. Molecules, 24(13), 2432. https://doi.org/10.3390/molecules24132432

